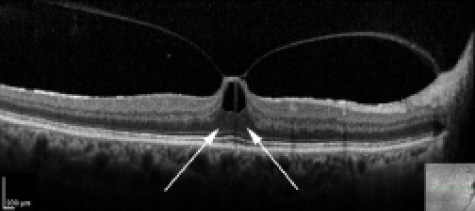

At a Glance
• Retina specialists considering surgical or
pharmacologic intervention to resolve VMT
should take a patient's ocular history into
account when deciding on treatment.
• Prior anti-VEGF use may predict spontaneous
posterior vitreous detachment in patients
with VMT.
• In a small retrospective study, VMT in patients
who only had inner retinal involvement was more
likely to resolve than in patients with both inner
and outer retinal involvement.
The prevalence of vitreomacular traction (VMT) associated with ocular disease has been estimated to range from 0.35% to 1.5% of the general population, suggesting a large disease burden and potentially large treatment demand.1 Vitreous traction on the macula is due to anomalous and incomplete posterior vitreous detachment, and it may be associated with other conditions such as age-related macular degeneration (AMD), diabetic macular edema (DME), or retinal vein occlusion (RVO). In cases of VMT, tractional forces induce structural changes in the retina, leading to loss of central vision and metamorphopsia.
Previously, we and other authors have shown that spontaneous resolution of VMT without pharmacologic or surgical intervention occurs and may be associated with improvement in visual acuity and elimination of VMT symptomatology.2 Recently, we set out to determine which factors, if any, might predict or be associated with spontaneous separation and resolution of VMT.3 We aimed to identify predictive factors to aid clinicians in the decision of when to observe patients with VMT versus when to proceed with pars plana vitrectomy or pharmacologic vitreolysis.

Figure 1. Spectral-domain optical coherence tomography (SD-OCT) scan of a patient with VMT and subsequent spontaneous release. There is a focal area of abnormal adhesion at the fovea with associated traction and distortion of the inner retina. Note how the outer retina is unaffected (A). After 6 months of observation, the VMT resolved with improved foveal contour and normal inner retinal architecture (B).
RETROSPECTIVE INVESTIGATION
We retrospectively investigated 61 patients with VMT as seen on optical coherence tomography (OCT) and excluded any patient with previous surgery or prior treatment with ocriplasmin (Jetrea, ThromboGenics). VMT was characterized for each patient as broad (> 400 µm) or focal (< 400 µm) based on horizontal OCT scans.
Classification and Parameters
VMT was classified by the degree of inner-only versus both inner and outer retinal involvement. Patients with inner retina distortion showed VMT causing abnormal inner retinal architecture up to, but not including, the outer nuclear layer. These patients also showed normal outer retinal anatomy, including a normal external limiting membrane and photoreceptor ellipsoid zone. Patients were classified as having combined inner and outer retina involvement if the outer retinal architecture was also involved. Patients with concurrent exudative AMD, DME, and macular edema associated with RVO received anti-VEGF injections independent of a diagnosis of VMT. Spontaneous resolution of VMT was defined as a release of traction from all macular points seen on OCT without vitrectomy or ocriplasmin injection.
Results
Over an observation period of approximately 1 year, we found that 21 of 61 (35%) patients experienced VMT resolution and 40 of 61 (65%) did not. Patients with spontaneous release of VMT were significantly more likely to have only inner retinal distortion (P = .01; Figure 1). VMT with solely inner retina disruption is commonly referred to as possessing the column sign, owing to the outer retina being undisturbed in the configuration of two columns (Figure 2). Patients with VMT involving both the inner and outer retina (Figure 3) were unlikely to have spontaneous release of their retinal distortion.
Figure 2. SD-OCT scan of a patient with VMT depicting the column sign. There is a focal area of abnormal adhesion resulting in VMT distorting the subfoveal and perifoveal inner retina. The outer retina remains intact and resembles two columns (white arrows). Note the intact external limiting membrane and continuous ellipsoid zone.

Figure 3. SD-OCT scans of a patient with VMT with varying inner and outer retinal distortion along with loss of the photoreceptor ellipsoid zone. The VMT persisted over the course of 4 months, and the patient elected definitive pars plana vitrectomy.
Binary logistic regression analysis and calculation of odds ratio was performed, and we found that patients with VMT only involving the inner retina were 10.45 times more likely to have release of their VMT compared with patients with both inner and outer retina involvement.
For patients with concurrent exudative AMD, DME, and macular edema due to RVO, previous treatment with intravitreal injections of anti-VEGF was associated with a higher incidence of VMT release; these patients were 7.39 times more likely to have spontaneous release of VMT compared with patients not receiving intravitreal injections. Additionally, patients with both inner retina involvement and a history of receiving intravitreal injections were 16.28 more likely to have spontaneous release of their VMT. Prior use of intravitreal injections was also shown to potentially mechanically induce posterior vitreous detachment (P = .02).
No difference was observed in the rate of VMT release for patients with focal adhesions on the macula compared with patients with broad adhesions on the macula. Multifocal VMT was noted in a small number of cases and associated with a lack of spontaneous release.
CONCLUSION
Spontaneous release of VMT was observed in 35% of patients in a small retrospective study. By comparison, in the MIVI trials, which observed the rate of VMT resolution in patients injected with ocriplasmin versus placebo, 10% of patients injected with placebo and 26.5% of patients injected with ocriplasmin had release of VMT at day 28 (P < .001).4 We have previously shown that case selection is paramount for success with pharmacologic vitrolysis5; thus, observation would provide a valuable tool in the armamentarium of the vitreoretinal physician.
In our study, patients with only inner retinal distortion on OCT and those receiving multiple intravitreal injections were significantly more likely to have spontaneous release of VMT. These findings are especially important in the management of patients with AMD, DME, and retinal vascular disease who typically need and receive multiple anti-VEGF injections. If such patients have only inner retinal distortion on OCT, it would be reasonable to follow them with observation alone, as the traction is likely to resolve spontaneously and the continued treatment with intravitreal injections may further increase the likelihood of VMT release.
We believe these findings are of value to the clinician in evaluating patients with VMT—especially in the setting of those who have concomitant retinal diseases—by providing real-world clinical evidence of the likelihood of disease resolution. n

David R.P. Almeida, MD, MBA, PhD, is a vitreoretinal surgeon at VitreoRetinal Surgery, PA, in Minneapolis, Minn. He has no relevant financial discloses. Dr. Almeida may be reached at dalmeida@evolation-medical.com.

Eric K. Chin, MD, is a vitreoretinal surgeon at the Retina Consultants of Southern California in Riverside, Calif. Dr. Chin may be reached at chin.eric@gmail.com.
1. Stalmans P, Duker JS, Kaiser PK, et al. OCT-based interpretation of the vitreomacular interface and indications for pharmacologic vitreolysis. Retina. 2013;33(10):2003-2011.
2. Almeida DRP, Chin EK, Russell SRR. Spontaneous resolution of vitreomacular traction in two patients with diabetic macular edema. Case Rep Ophthalmol. 2014; 5(1):66-71.
3. Almeida DR, Chin EK, Rahim K, et al. Factors associated with spontaneous release of vitreomacular traction. Retina. 2015;35(3):492-497.
4. Stalmans P, Benz MS, Gandorfer A, et al. MIVI-TRUST Study Group. Enzymatic vitreolysis with ocriplasmin for vitreomacular traction and macular holes. N Engl J Med. 2012;367(7):606-615.
5. Chin EK, Almeida DR, Sohn EH, et al. Incomplete vitreomacular traction release using intravitreal ocriplasmin. Case Rep Ophthalmol. 2014;5(3):455-462.



















